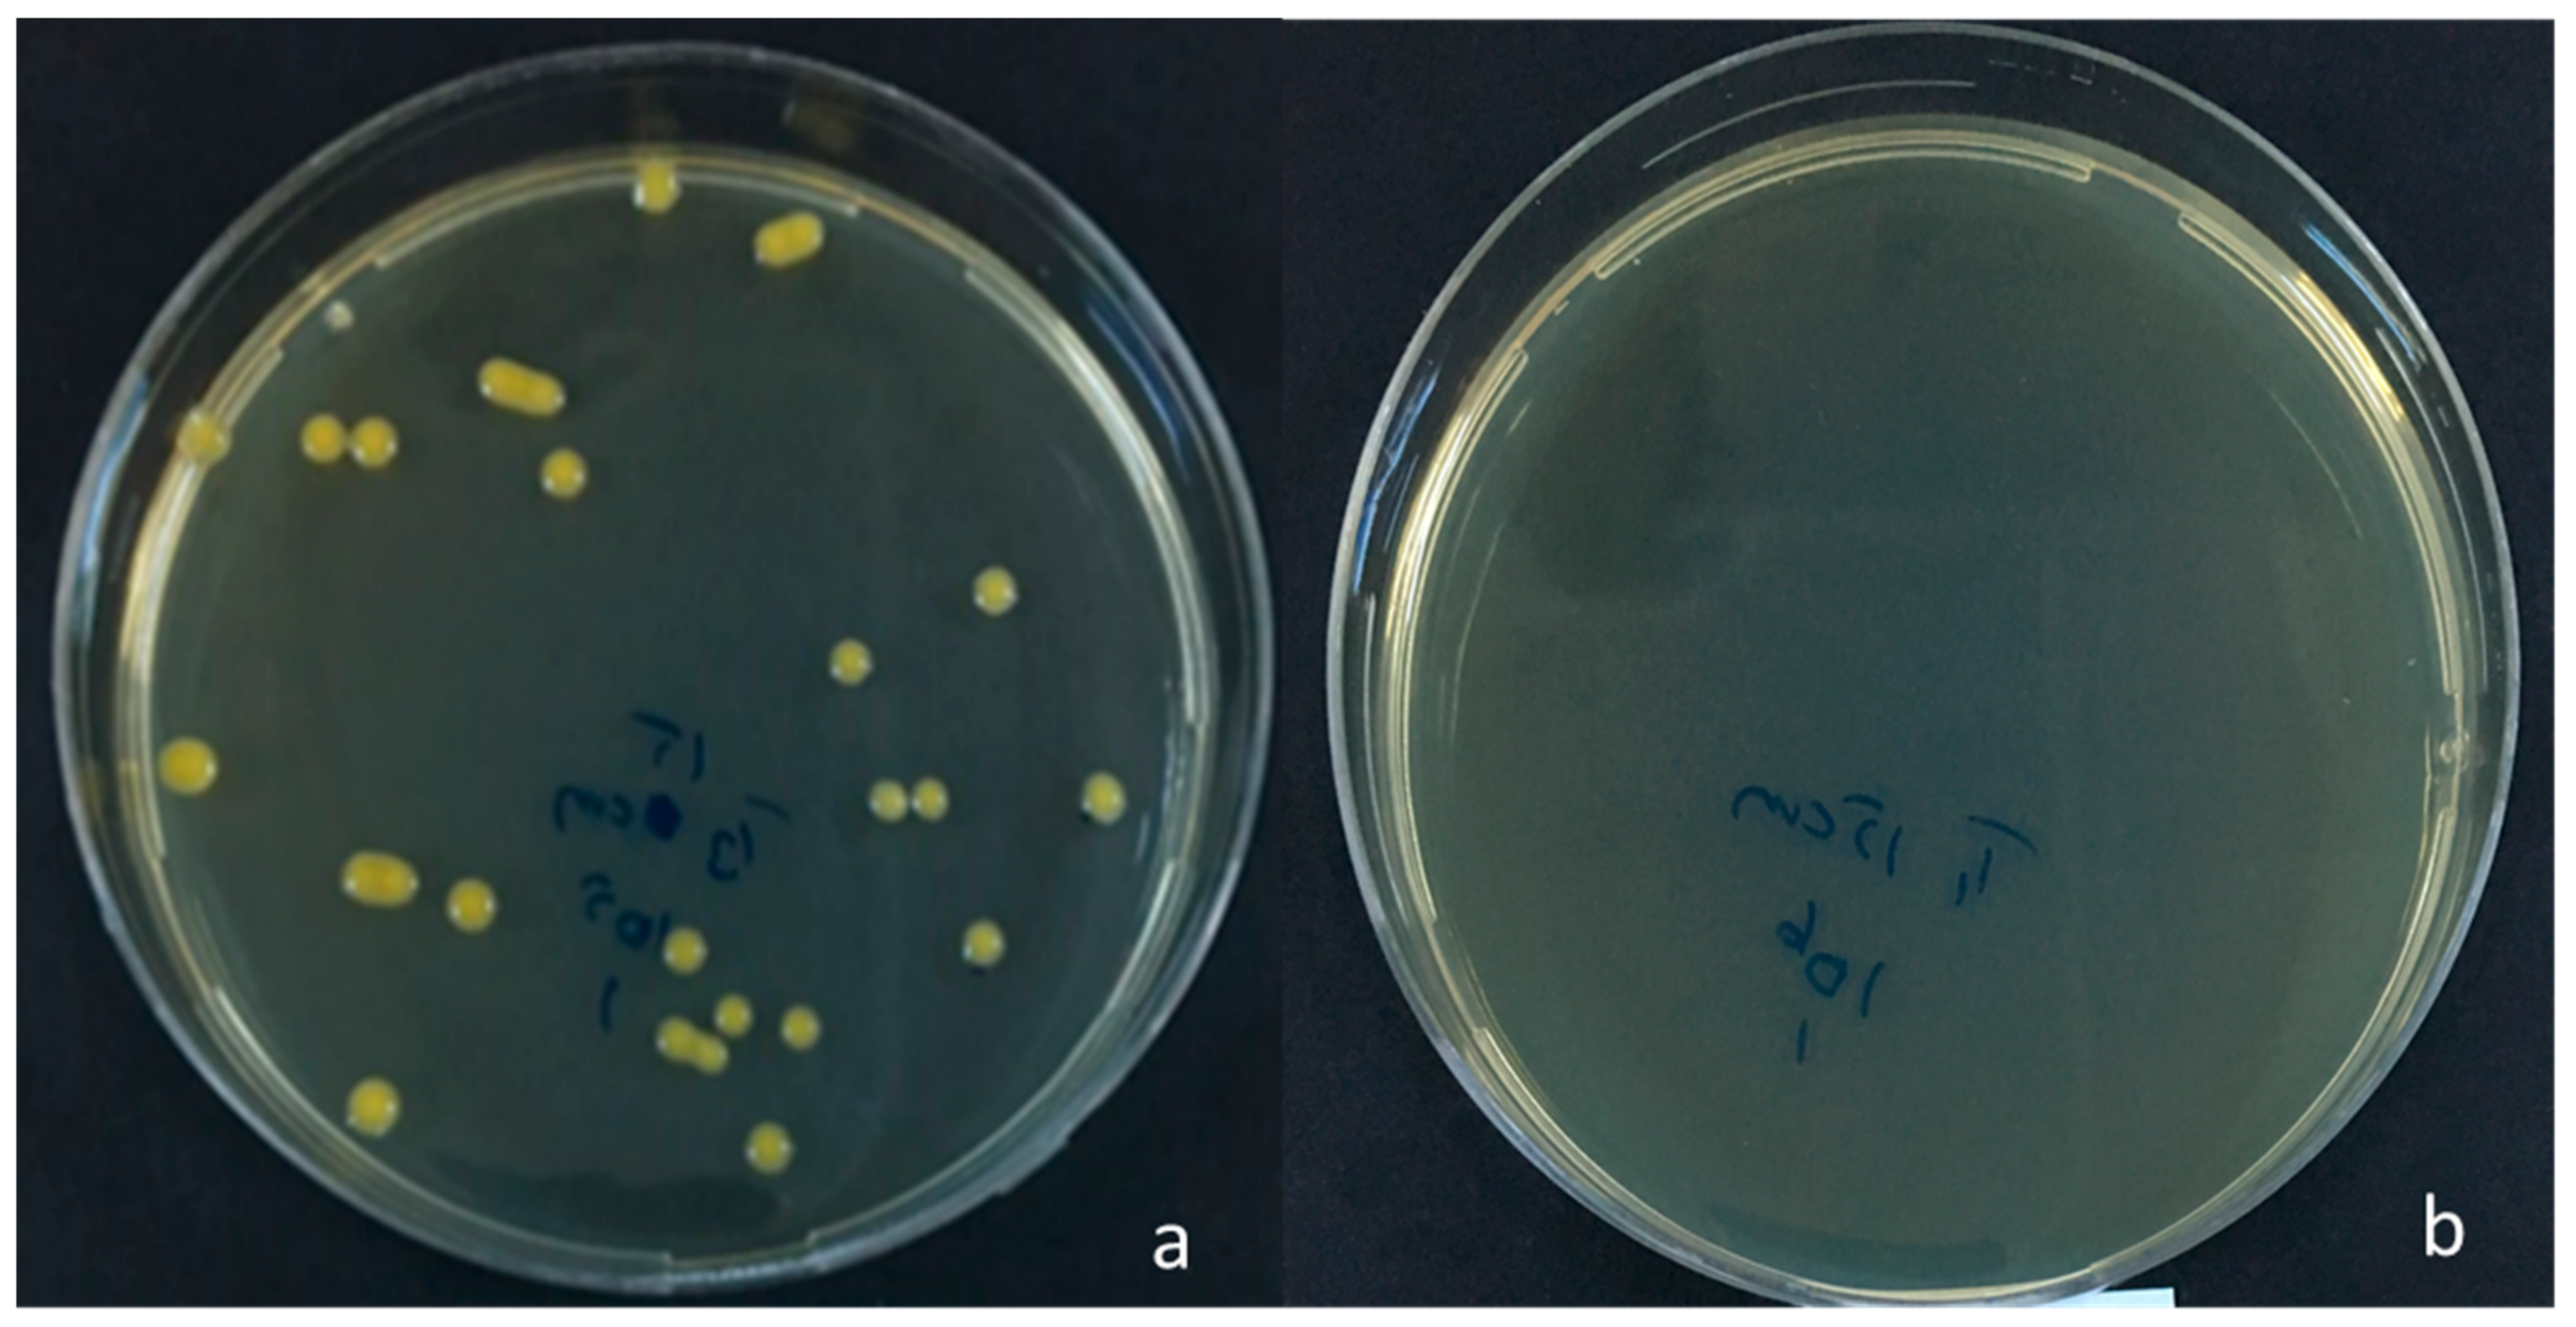
Agronomy 13 00677 g002
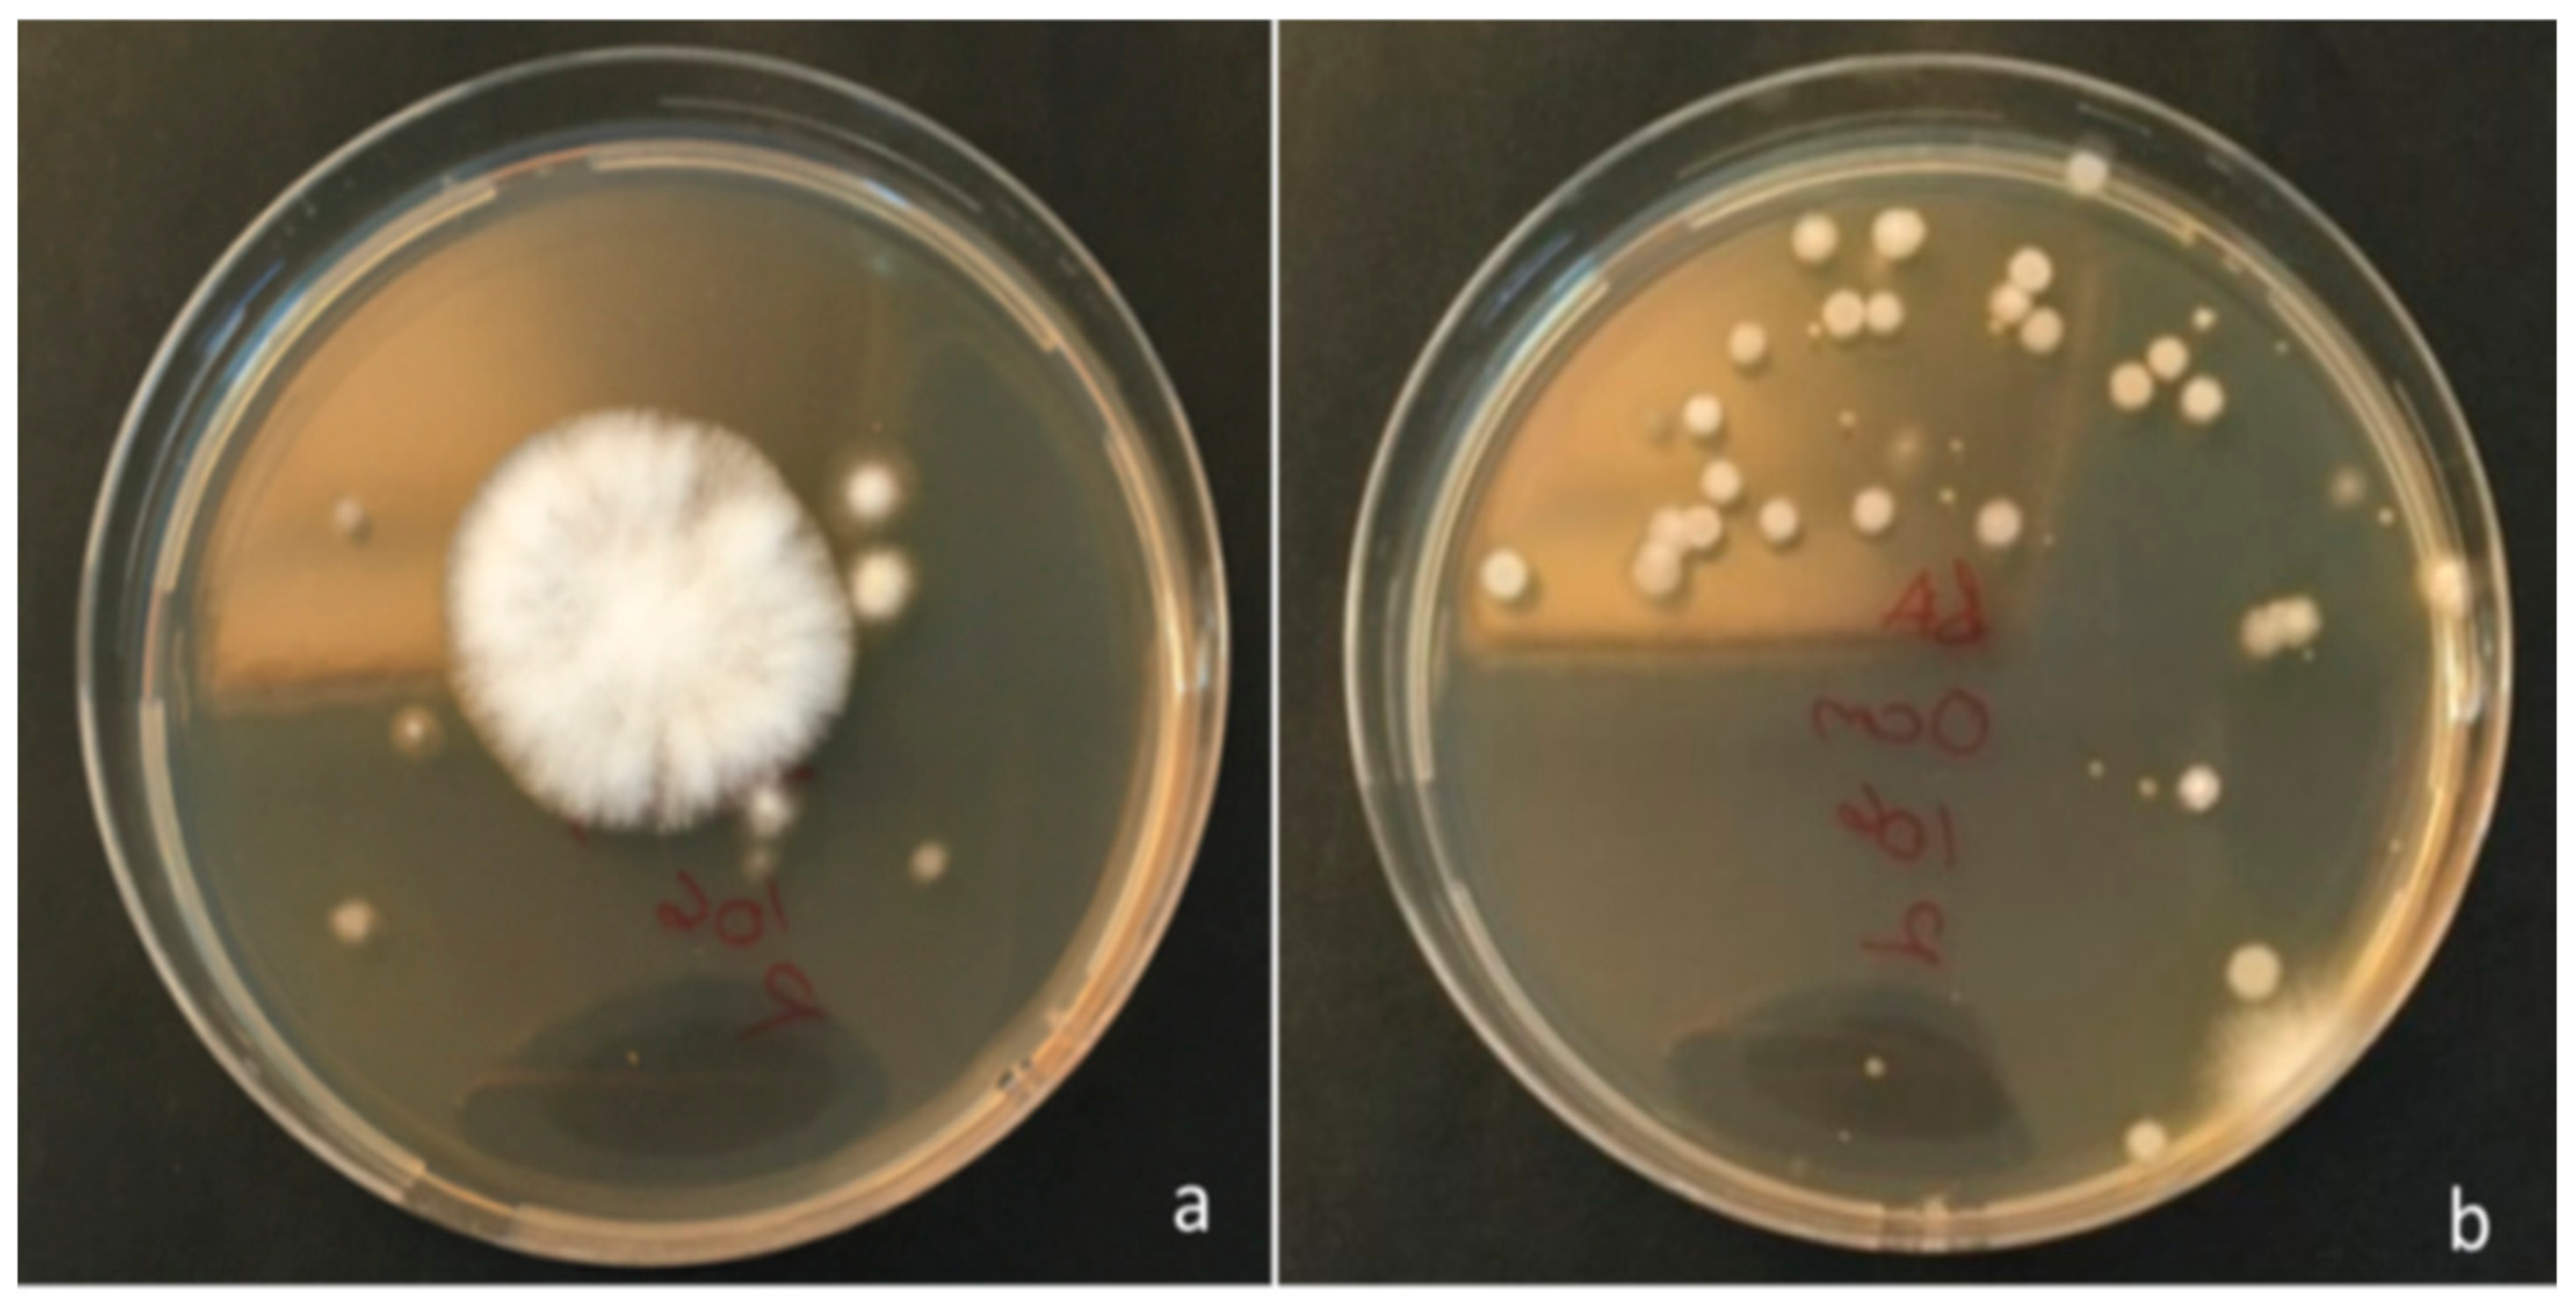
Agronomy 13 00677 g003

Epidemiology of Xanthomonas euvesicatoria in Tokat Province
Abstract
1. Introduction
2. Material and Method
2.1. Determination of the Lifespan of Xanthomonas euvesicatoria in Inoculated Seed
2.2. Determination of the Lifespan of Xanthomonas euvesicatoria in Inoculated Soil
2.3. Determination of the Lifespan of Xanthomonas euvesicatoria in Plant Residues in Soil
3. Results
3.1. Lifespan of Xanthomonas euvesicatoria in Inoculated Seed
3.2. Lifespan of Xanthomonas euvesicatoria in Inoculated Soil
3.3. Lifespan of Xanthomonas euvesicatoria in Plant Residues
4. Discussion
5. Conclusions
Author Contributions
Funding
Data Availability Statement
Conflicts of Interest
References
- Doidge, E.M. A tomato cancer. J. Dep. Agric. Union S. Afr. 1920, 1, 718–721. [Google Scholar]
- FAO. 2020. Available online: https://www.fao.org/faostat/en/#home (accessed on 6 January 2022).
- Jones, J.; Lacy, G.; Bouzar, H.; Stall, R.; Schaad, N. Reclassification of the xanthomonads associated with bacterial spot disease of tomato and pepper. Syst. Appl. Microbiol. 2006, 27, 755–762, Erratum in Syst. Appl. Microbiol. 2006, 29, 85–86. [Google Scholar] [CrossRef] [PubMed]
- Vauterin, L.; Swings, J.; Kersters, K.; Gillis, M.; Mew, T.W.; Schroth, M.N.; Palleroni, N.J.; Hildebrand, D.C.; Stead, D.E.; Civerolo, E.L.; et al. Towards and improved taxonomy of Xanthomonas. Int. J. Syst. Bacteriol. 1990, 40, 312–316. [Google Scholar] [CrossRef]
- Sutıc, D. Bakterioze crvenog patlidzana (Tomato Bacteriosis). In Posebna Izd Inst Zasht Bilja Beograd; Special Edition; Institute of Plant Protein: Beograd, Serbia, 1957; Volume 6, pp. 1–65. [Google Scholar]
- Bouzar, H.; Jones, J.B.; Somodi, G.C.; Stall, R.E.; Daouzli, N.; Lambe, R.C.; Felix-Gastelum, R.; Trinidad-Correa, R. Xanthomonas campestris pv. vesicatoria race variation in tomato and pepper Fields of Mexico. Can. J. Plant Pathol. 1996, 18, 75–77. [Google Scholar] [CrossRef]
- Stall, R.E.; Jones, J.B.; Minsavage, G.V. Durability of resistance in tomato and pepper to xanthomonads causing bacterial spot. Annu. Rev. Phytopathol. 2009, 47, 265–284. [Google Scholar] [CrossRef]
- Saygılı, H.; Aysan, Y.; Şahin, F.; Soylu, S.; ve Mirik, M. Bitki Bakteri Hastalıkları; Tekirdağ Namık Kemal Üniversitesi: Tekirdağ, Turkey, 2019; ISBN 978-6054-2655-4-1. Yayın no: 2.08-025-0028/B-1.syf no; 249–255. [Google Scholar]
- EPPO. 2022. Available online: https://gd.eppo.int/taxon/XANTVE/distribution (accessed on 26 February 2022).
- Karaca, İ.; Saygılı, H. Batı Anadolu’nun Bazı Illerinde Domates ve Biberlerde Görülen Bakteriyel Hastalıkların Oranı, Etmenleri, Belirtileri ve Konukçu Çeşitlerinin Duyarlılığı Üzerine Araştırmalar. III. In Proceedings of the Türkiye Fitopatoloji Kongresi Bildiri Özetleri, Adana, Turkey, 12–15 October 1982; pp. 182–192. [Google Scholar]
- Erkan, S.; Saygılı, H. The preliminary studies on the isolation of the bacteriophages of some phytopathogenic bacteria. J. Turk. Phytopathol. 1987, 16, 71–76. [Google Scholar]
- Basım, E.; Basım, H.; Dickstein, E.R.; Jones, J.B. Bacterial canker caused by Clavibacter michiganensis subsp. michiganensis on greenhouse tomato in the Western Mediterranean Region of Turkey. Plant Dis. 2004, 88, 1048. [Google Scholar] [CrossRef]
- Şahın, F. Pepper races 7,8 and 10 of Xanthomonas axonopodis pv vesicatoria isolated From Diseased Pepper Plants in Turkey. Plant Pathol. 2001, 50, 809. [Google Scholar] [CrossRef]
- Aysan, Y.; Sahın, F. Occurrence of bacterial spot disease, caused by Xanthomonas axonopodis pv. vesicatoria, on pepper in the eastern Mediterranean region of Turkey. Plant Pathol. 2003, 52, 781. [Google Scholar] [CrossRef]
- TUIK. 2020. Available online: https://biruni.tuik.gov.tr/medas/?kn=104&locale=tr (accessed on 8 October 2022).
- Kayaaslan, Z. Tokat İli Biber Üretim Alanlarında Bakteriyel Leke Hastalığı Etmeni (Xanthomonas euvesicatoria)’nin Tanılanması, Epidemiyolojisi ve Biyolojik Mücadelesi. Ph.D. Thesis, Gaziosmanpaşa Üniversitesi, Lisansüstü Eğitim Enstitüsü, Bitki Koruma Anabilim Dalı, Tokat, Türkiye, 2021. [Google Scholar]
- Belgüzar, S.; Yanar, Y.; ve Aysan, Y. Tokat İlinde Domates Bakteriyel Solgunluk Hastalığının Yaygınlığı ve Etmenin (Clavibacter michiganensis subsp. michiganensis) Tanılanması. J. Agric. Fac. Gaziosmanpasa Univ. 2016, 33, 34–40. [Google Scholar] [CrossRef]
- Sun, X.; Nielsen, M.C.; Miller, W. Bacterial Spot of Tomato and Pepper. In Plant Pathology Circular No. 129 (Revised); Florida Department of Agriculture & Consumer Services, Division of Plant Industry: Tallahassee, FL, USA, 2002. [Google Scholar]
- Bashan, Y.; Dıab, S.; Okan, Y. Survival of Xanthomonas campestris pv vesicatoria in pepper seeds and roots in symptomless and dry leaves in non-host plants and in the soil. Plant Soil 1982, 68, 161–170. [Google Scholar] [CrossRef]
- Jones, J.B.; Lacy, G.H.; Bouzar, H.; Stall, R.E.; Schaad, N.W. Reclassification of the Xanthomonas associated with bacterial spot disease of tomato and pepper. Syst. Appl. Microbiol. 2004, 27, 755–762. [Google Scholar] [CrossRef] [PubMed]
- Giovanardi, D.; Biondi, E.; Perez, S. Seed Transmission of Xanthomonas vesicatoria and Clavibacter michiganensis subsp. michiganensis in Tomato and Xanthomonas euvesicatoria in Pepper and Implementation of Seed Disinfection Methods. In Proceedings of the VII Congress on Plant Protection; Macic, D., Glavendekc, M., Nicot, P., Eds.; Plant Protection Society of Serbia: Belgrade, Serbia, 2015; pp. 53–58. [Google Scholar]
- Diab, S.; Bashan, Y.; Okan Yand Henis, Y. Effect of Relative Humudity on Bacteria Scab Caused by Xanthomonas campestris pv. vesicatoria on pepper. Ecol. Epidemiol. 1982, 72, 1257–1260. [Google Scholar]
- Beran, P.; Mraz, I.; Kokoskova, B.; Bohata, A. Monitoring the occurrence of bacterial spot of tomato and pepper in the Czech Republic and development of new PCR primers for detection of Xanthomonas vesicatoria. Eur. J. Plant Pathol. 2015, 141, 617–621. [Google Scholar] [CrossRef]
- Simonton, T.E.; Robinson, D.; Gillard, C.; Jordan, K.; Trueman, C.L. Transmission of Xanthomonas gardneri to tomato seedlings during transportation and transplanting. Crop Prot. 2021, 141, 105472. [Google Scholar] [CrossRef]
- Bernal, R.F.; Berger, R.D. The Spread of Epiphytic Populations of Xanthomonas campestris pv. vesicatoria on Pepper in the Field. J. Phytopathol. 1996, 144, 479–484. [Google Scholar] [CrossRef]
- Kim, J.-H.; Kang, W.-S.; Yun, S.-C. Development of a Model to Predict the Primary Infection Date of Bacterial Spot (Xanthomonas campestris pv. vesicatoria) on Hot Pepper. Plant Pathol. J. 2014, 30, 125–135. [Google Scholar] [CrossRef]
- Potnis, N.; Imılsın, S.; Strayer, A.; Shantharaj, D.; Barak, J.D.; Paret, M.L.; Vallad, G.E.; Jones, J. Bacterial spot of tomato and pepper: Diverse Xanthomonas species with a wide variety of virulence factors posing a worldwide challenge. Mol. Plant Pathol. 2015, 16, 907–920. [Google Scholar] [CrossRef]
- Şahın, F. Detection, Identification and Characterization of Strains of Xanthomonas campestris pv. vesicatoria by Traditional and Moleculer Methods, and Resistance in Capsicum Species to Xanthomonas campestris pv. vesicatoria Pepper Race 6. Ph.D. Thesis, The Ohio State University, Columbus, OH, USA, 1997; p. 181. [Google Scholar]
- Mirik, M.; Aysan, Y. Detectıon of Xanthomonas axonopodıs pv. vesıcatoria. in Naturally Infected pepper Seeds in Turkey. J. Plant Pathol. 2009, 91, 433–436. [Google Scholar]
- Jones, J.B.; Pohronezny, K.L.; Stall, R.E.; Jones, J.P. Survival of Xanthomonas campestris pv. vesicatoria in Florida on tomato crop, residue, weeds, seeds, and volunteer tomato plants. Phytopathology 1986, 76, 430–434. [Google Scholar] [CrossRef]
- Belgüzar, S.; Yanar, Y.; Aysan, Y. Tokat İlinde Domates Bakteriyel Solgunluk Hastalığı’nın (Clavibacter michiganensis subsp. michiganensis) Epidemiyolojisi. J. Tekirdag Agric. Fac. 2018. [Google Scholar]
- Mariano, R.L.R.; McCarter, S.M. Pseudomonas syringae pv. tomato, P. syringae pv. syringae and P. viridiflava: Survival on seeds and epiphytic growth on tomato seedlings originated from contaminated seeds. Summa Phytopathol. 1992, 18, 247–254. [Google Scholar]
- Hankin, L.; Sands, D.S. Microwave treatment of tobacco seed to eliminate bacteria on the seed surface. Phytopathology 1976, 67, 794–795. [Google Scholar] [CrossRef]
- Aysan, Y.; Sahin, F.; Cetinkaya-Yildiz, R.; Mirik, M.; Yucel, Y. Occurence and primer inoculum sources of bacterial stem rot caused by Erwinia species on tomato in the eastern Mediterraanean region of Turkey. J. Plant Dis. Prot. 2005, 112, 42–51. [Google Scholar]
- Zitter, T.A. Pepper Disease Control It Starts with the Seed; Department of Plant Pathology, Cornell University: Ithaca, NY, USA, 2004; p. 14853. [Google Scholar]
- Peterson, G.H. Survival of Xanthomonas vesicatoria in soil and diseased tomato plants. Phytopathology 1963, 53, 765–767. [Google Scholar]
- Jones, J.B.; Bouzar, H.; Somodi, G.C.; Stall, R.E.; Pernezny, K.; El-Morsy, G.; Scott, J.W. Evidence for the preemptive natüre of tomato race 3 of Xanthomonas campestris pv. vesicatoria in Florida. Phytopathology 1998, 88, 33–38. [Google Scholar] [CrossRef]

| Day | Percentage of İnfected Seeds with Xeu (%) |
|---|---|
| 0. Day | 100 ± 0.33 a |
| 33. Day | 86 ± 0.58 b |
| 66. Day | 78 ± 0.67 b |
| 100. Day | 66 ± 0.00 c |
| 129. Day | 58 ± 0.33 c |
| 160. Day | 40 ± 0.00 d |
| 193. Day | 4 ± 0.00 e |
| 220. Day | 1 ± 0.33 e |
| 249. Day | 0 ± 0.00 e |
| Days | Summer Term Bacterial Density | Winter Term Bacterial Density | ||
|---|---|---|---|---|
| 0 cm | 15 cm | 0 cm | 15 cm | |
| 0. day | 7.9 × 10−8 | 7.9 × 10−8 | 8.6 × 10−8 | 8.6 × 10−8 |
| 7. days | 2 × 10−4 | 2 × 10−4 | 4.6 × 10−4 | 5.0 × 10−4 |
| 14. days | 2 × 10−4 | 2 × 10−4 | 0.5 × 10−4 | 0 |
| 21. days | 0 | 2 × 10−4 | 0 | 0 |
| 28. days | 1.5 × 10−4 | 2.5 × 10−4 | 0 | 0 |
| 35. days | 1 × 10−4 | 2.5 × 10−4 | 0 | 0 |
| 42. days | 0 | 0 | 0 | 0 |
| 49. days | 2.5 × 10−4 | 1 × 10−4 | 0 | 0 |
| 56. days | 1.5 × 10−4 | 2 × 10−4 | 0 | 0 |
| 63. days | 0 | 1.5 × 10−4 | 0 | 0 |
| 70. days | 1 × 10−4 | 1.0 × 10−4 | 0 | 0 |
| 77. days | 0 | 0 | 0 | 0 |
| 84. days | 0 | 0 | 0 | 0 |
| 91. days | 0 | 0 | 0 | 0 |
| 98. days | 0 | 0 | 0 | 0 |
| 105. days | 1.0 × 10−4 | 1.0 × 10−4 | 0 | 0 |
| 112. days | 0 | 0 | 0 | 0 |
| Days | Summer Term Bacterial Density | Winter Term Bacterial Density | ||
|---|---|---|---|---|
| 0 cm Depth (Cell/g) | 20 cm Depth (Cell/g) | 0 cm Depth (Cell/g) | 20 cm Depth (Cell/g) | |
| 0. day | 6.3 × 10−8 ± 0.58 a | 6.3 × 10−8 ± 0.58 a | 5.4 × 10−8 ± 0.58 a | 5.4 × 10−8 ± 0.58 a |
| 15. days | 15 × 10−6 ± 0.00 b | 5 × 10−6 ± 0.58 b | 2 × 10−6 ± 0.00 b | 1 × 10−6 ± 0.00 b |
| 30. days | 10 × 10−6 ± 0.58 c | 1 × 10−6 ± 0.00 c | 1 × 10−6 ± 0.00 b | 0 ± 0.00 c |
| 45. days | 1 × 10−6 ± 0.00 d | 0 ± 0.00 d | 0 ± 0.00 c | 0 ± 0.00 c |
| 60. days | 1 × 10−6 ± 0.00 d | 0 ± 0.00 d | 0 ± 0.00 c | 0 ± 0.00 c |
| 75. days | 0 ± 0.00 e | 0 ± 0.00 d | 0 ± 0.00 c | 0 ± 0.00 c |
| 90. days | 0 ± 0.00 e | 0 ± 0.00 d | 0 ± 0.00 c | 0 ± 0.00 c |
Disclaimer/Publisher’s Note: The statements, opinions and data contained in all publications are solely those of the individual author(s) and contributor(s) and not of MDPI and/or the editor(s). MDPI and/or the editor(s) disclaim responsibility for any injury to people or property resulting from any ideas, methods, instructions or products referred to in the content. |
© 2023 by the authors. Licensee MDPI, Basel, Switzerland. This article is an open access article distributed under the terms and conditions of the Creative Commons Attribution (CC BY) license (https://creativecommons.org/licenses/by/4.0/).
Share and Cite
Kayaaslan, Z.; Belgüzar, S.; Yanar, Y.; Mirik, M. Epidemiology of Xanthomonas euvesicatoria in Tokat Province. Agronomy 2023, 13, 677. https://doi.org/10.3390/agronomy13030677
Kayaaslan Z, Belgüzar S, Yanar Y, Mirik M. Epidemiology of Xanthomonas euvesicatoria in Tokat Province. Agronomy. 2023; 13(3):677. https://doi.org/10.3390/agronomy13030677
Chicago/Turabian StyleKayaaslan, Zeliha, Sabriye Belgüzar, Yusuf Yanar, and Mustafa Mirik. 2023. "Epidemiology of Xanthomonas euvesicatoria in Tokat Province" Agronomy 13, no. 3: 677. https://doi.org/10.3390/agronomy13030677
APA StyleKayaaslan, Z., Belgüzar, S., Yanar, Y., & Mirik, M. (2023). Epidemiology of Xanthomonas euvesicatoria in Tokat Province. Agronomy, 13(3), 677. https://doi.org/10.3390/agronomy13030677

